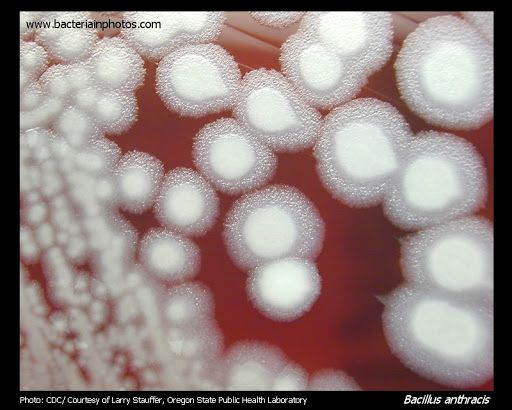

12.下列何種細菌,在sheep blood agar上形成不溶血菌落,邊緣不規則,有往外生長的長絲狀
突起,外觀如medusa head?
(A)Bacillus anthracis
(B)Bacillus cereus
(C)Corynebacterium pseudotuberculosis
(D)Erysipelothrix rhusiopathiae
答案:登入後查看
統計: A(1507), B(94), C(105), D(97), E(0) #926998
統計: A(1507), B(94), C(105), D(97), E(0) #926998